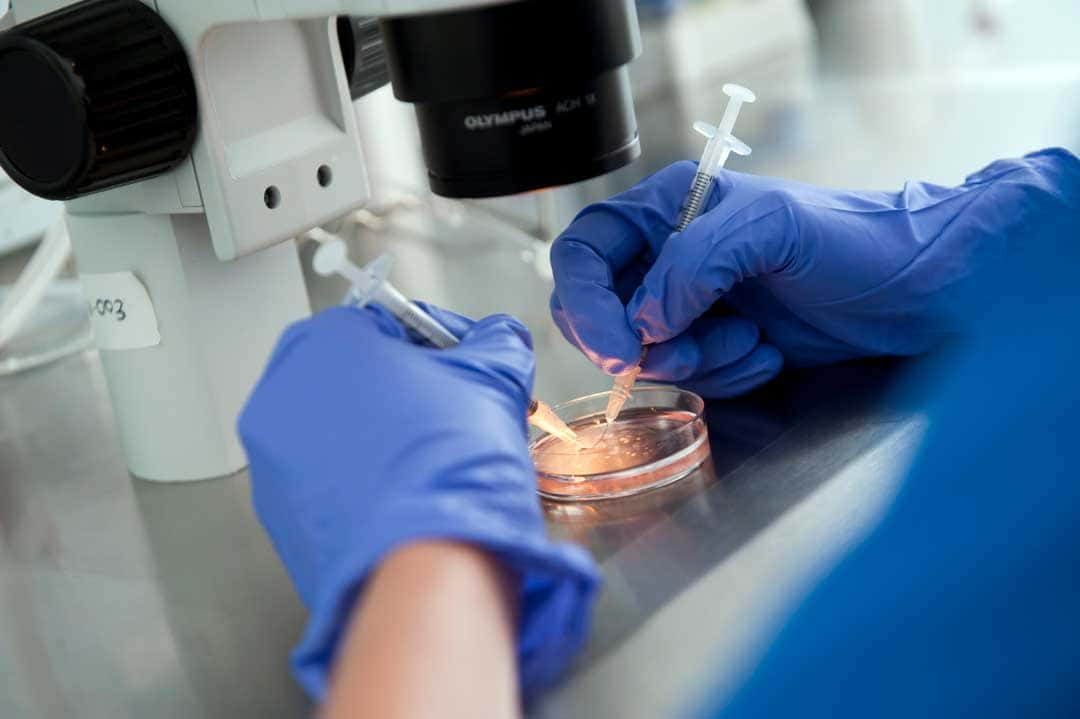

Endogen es un tratamiento avanzado de regeneración endometrial, diseñado específicamente para mejorar las condiciones del útero y aumentar las posibilidades de tener a tu bebé.
Este tratamiento es seguro y eficaz, y ha demostrado ser una opción ideal para mujeres que enfrentan dificultades en la implantación embrionaria durante procesos de Fertilización In Vitro (FIV).
Su principal objetivo es preparar el endometrio, creando un ambiente adecuado para que el embrión se implante de manera exitosa y se desarrolle un embarazo saludable.
El endometrio, la capa interna del útero, juega un papel crucial en el éxito de la implantación del embrión. Si este tejido no está en condiciones óptimas, el embrión puede tener dificultades para adherirse y continuar su desarrollo.
Endogen actúa mejorando la calidad de este tejido, promoviendo su regeneración y optimizando su receptividad.
Esto se logra a través de la estimulación de la regeneración celular y la restauración de un entorno uterino saludable, lo que facilita la implantación del embrión y, por ende, incrementa las tasas de éxito en tratamientos de reproducción asistida.